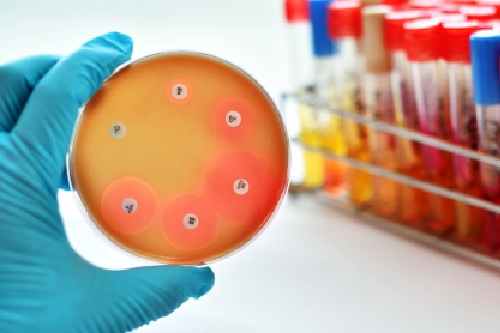

Noticias
Propagación del candidozyma auris resistente a medicamentos
La última encuesta del Centro Europeo para la Prevención y el Control de las Enfermedades (ECDC), la cuarta de este tipo, confirma que Candidozyma auris (antes Candida auris) sigue propagándose rápidamente por los hospitales europeos, lo que supone una grave amenaza para los pacientes y los sistemas sanitarios. El número de casos está aumentando, los brotes están creciendo en escala y varios países informan de una transmisión local continua. Los resultados ponen de relieve la importancia de la detección precoz y el control de la transmisión para evitar una rápida propagación generalizada.
Fuente: ECDC